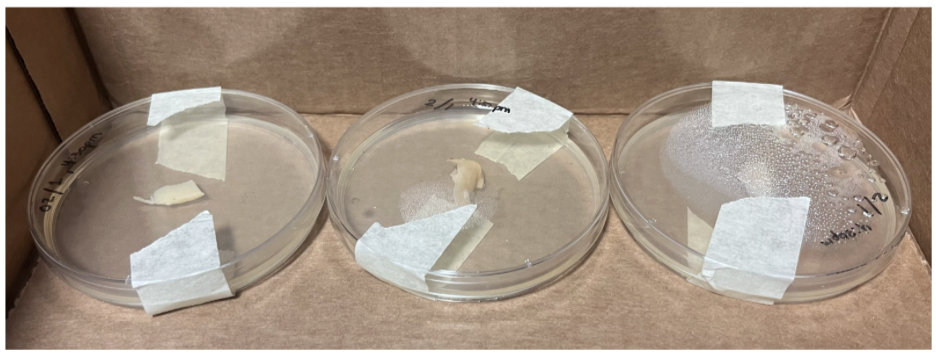

Communicating Science through Art

Contribution to Silences Science Stories Project, May 2025


Other inquiries….
I’m very interested in the ways in which art and science overlap and in the potential solutions that lie at their intersection.



What if there was a way to make a “living” photograph? Is there a substance out there that responds to light enough to become its own print? (Maybe, I know that chlorophyll has produced some results).
What if we completely rethought the textile industry? What if our clothes were made of mycelium or algae?


What if I went to that underground bio-design conference that a company invited me through after some back-and-forth emailing? What if it was 100% in German yet I sat through the entire thing anyway? I might learn all about interlocking building materials, dyes made from fungi, and plastics made from algae…
What if I made tiny sculptures to image on the confocal, kind of like the images I take of the Drosophila dissections I perform in lab? Do some things naturally fluoresce? How can I dye substances with fluorescence without a protocol?
What if I 3-D printed a 120mm camera with an adapter for a Mamiya lens?
Could I use mycelium to make sculptures that I then photograph?
What if concrete contained microbial communities and could heal itself upon cracking? What if we could recycle and reuse concrete from demolished buildings?

In my lab, a peer of mine is working with microbes that “breathe” metals. This is so cool. How can we take advantage of electro-active microorganisms?
What would it look like to make a photographic series where one thing is made to look like it morphs slowly into another thing?
What are some possible advantages of being trained in both art and biology? How can we better communicate science?






